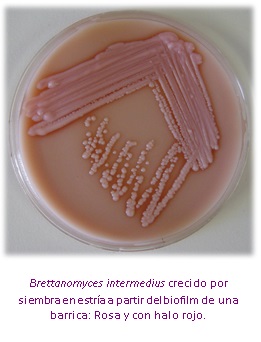
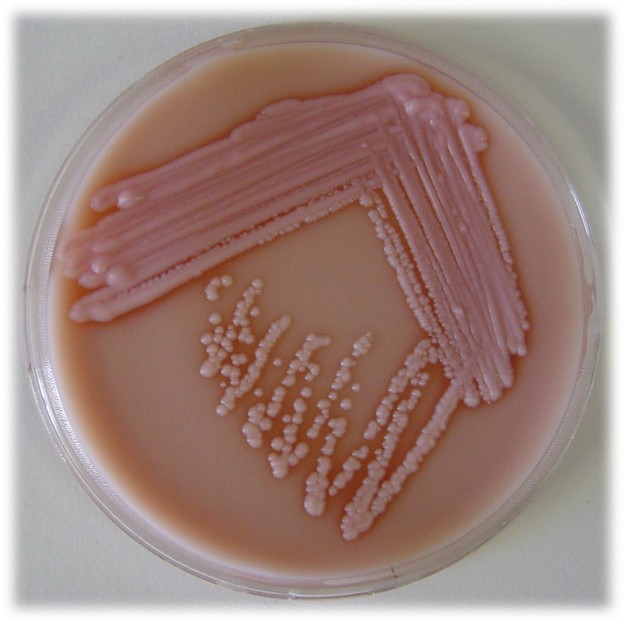

BRETTANOMYCES SELECTIVE MICROKIT AGAR. Detección y recuento de B.intermedius (=Dekkera bruxellensis) en vinos, barricas y otras fuentes
BRETTANOMYCES SELECTIVE MICROKIT AGAR. Detección y recuento de B.intermedius (=Dekkera bruxellensis) en vinos, barricas y otras fuentes
INTRODUCCIÓN
Brettanomyces intermedius (=Dekkera bruxellensis) es una levadura que en los ultimos tiempos se ha hecho tristemente famosa por el insoportable olor a ratón (o a establo) que produce en los vinos que tienen la mala fortuna de ser infectados por ella, hasta el punto de haberse tenido que quemar ya cientos de barricas para evitar la propagación de este grave deterioro de la calidad del buen vino. Actualmente es el agente de deterioro más temido en las bodegas, deterioro debido a los fenoles volátiles que produce, sobre todo al final de la fermentación alcohólica, justo cuando la bodega ha invertido tantos esfuerzos en sus vinos de crianza.
COMPOSICIÓN y PRESENTACIÓN
Este medio SELECTIVO y diferencial, fabricado por MICROKIT, contiene agentes nutritivos, selectivos y diferenciales y ha sido diseñado mediante una tesis doctoral por la Universidad de Salamanca y optimizado en colaboración de Laboratorios MICROKIT, S.L, a fin de mejorar los medios y kits que ya existían en el mercado y eran poco selectivos o complejos de manejar. La dificultad de su preparación hace inviable su comercialización en medio deshidratado. La volatilidad de algunos de sus componentes hacen totalmente inútil su intento de preparación en vial líquido para añadir a cartones absorbentes. Por eso la única opción es ofrecerlo en TUBOS PREPARADOS para refundir y elaborar placas en el momento. Y en PLAQUIS® herméticas. La extraordinariamente larga caducidad que conseguimos en los mismos, así como el carácter selectivo y diferencial de nuestra fórmula, hacen de ese producto el más útil y cómodo de emplear del mercado internacional.
PARA USO EXCLUSIVO EN LABORATORIO
MANTENGA LOS TUBOS Y PLAQUIS ® herméticas BIEN CERRADOS EN SU CAJA, EN LUGAR SECO, OSCURO Y FRESCO (entre 4-25°C pero sin oscilaciones de temperatura, que deshidratarían el medio).
CODIGO TUBOS: TPL937. CODIGO PLAQUIS ® herméticas PPL9BT.
CONTROL DE CALIDAD DEL MEDIO
Realizado en nuestro laboratorio; es prudente repetirlo en su laboratorio siempre que varíen las condiciones (más de 1 mes sin usar, tras desinfectar laboratorio, tras conservar a alta Tª, cuando adquiere aspectos extraños aunque no haya llegado la fecha de caducidad teórica de la etiqueta,…)
DESHIDRATADO: No existe. PREPARADO: Estéril, Opaco, con un tono rojo-rosado muy característico de este medio (“colorete cosmético”), con partículas/precipitados blanquecinos. pH final: 7,0 ± 0,2
CONTROL DE CRECIMIENTO 10-15 días a 28°C aproximadamente:
- Dekkera bruxellensis desde CBS 74T, Excelente, colonias de color rosado con halos casi transparentes alrededor y olor a vinagre o a ratón característico.
- Hanseniaspora uvarum desde CBS 314T, Buen crecimiento, pero sin halo ni olor característicos.
- Hanseniaspora vineae desde CBS 2171T, Buen crecimiento, pero sin halo ni olor característicos.
- Saccharomyces cerevisiae desde CBS 1171NT, No crece
- Saccharomyces bayanus desde CBS 380T, No crece.
MODO DE EMPLEO E INTERPRETACIÓN DE RESULTADOS
Fundir el tubo en agua hirviendo y cuando esté líquido, agitar, enfriando en agua fría. Cuando esté a 50°C, a punto de solidificar, y no antes, voltear suavemente hasta homogeneizar, abrir el tapón y verter en una placa Petri estéril. Dejar solidificar. También si usa PLAQUIS® herméticas preparadas: Inocular en la superficie de la placa preparada 0,5 ml de vino, borras…, extender con asa de Digralsky. Si el vino ya está a final de su crianza o embotellado, depositar sobre el medio la membrana de filtración de 0,45 µm por la que hayamos filtrado 10-100 ml.
Incubar 5-15 días en AErobiosis a (22)-28-30 ºC aprox., en atmósfera húmeda, o bien sellando la placa (si no utiliza PLAQUIS® herméticas de MICROKIT).
Dado el gran acierto de sus componentes, la recuperación es muy superior y mucho más selectiva a la de los otros medios comerciales.
Dar como confirmativas las colonias rosas, rodeadas de un halo transparente y rojo (por redisolución del carbonato) que se ve mejor sin membrana y con olor a vinagre, ratón, establo o cuero.
Si desea más información sobre nuestros MEDIO BRETTANOMYCES SELECTIVE MICROKIT AGAR, rellene nuestro formulario de contacto http://www.medioscultivo.com/contacto . O si lo prefiere póngase en contacto con nosotros a través de nuestro correo electrónico microkit@microkit.es o por teléfono en el nº 91-897 46 16
https://www.microkit.es/fichas/BRETANOMYCES-SELECTIVE-MICROKIT-AGAR.pdf